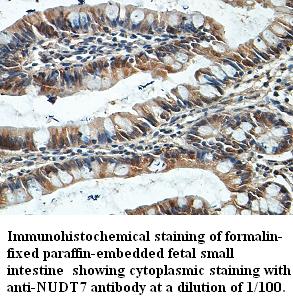

Immunohistochemical staining of human kidney shows strong cytoplasmic positivity in granular pattern in tubular cells.
Anti-NUDT7 Antibody
HPA042042
ApplicationsImmunoHistoChemistry
Product group Antibodies
ReactivityHuman
TargetNUDT7
Overview
- SupplierAtlas Antibodies
- Product NameAnti-NUDT7 Antibody
- Delivery Days Customer4
- ApplicationsImmunoHistoChemistry
- CertificationResearch Use Only
- ClonalityPolyclonal
- ConjugateUnconjugated
- Gene ID283927
- Target nameNUDT7
- Target descriptionnudix hydrolase 7
- Target synonymsperoxisomal coenzyme A diphosphatase NUDT7, nudix (nucleoside diphosphate linked moiety X)-type motif 7
- HostRabbit
- IsotypeIgG
- Protein IDP0C024
- Protein NamePeroxisomal coenzyme A diphosphatase NUDT7
- Scientific DescriptionRecombinant Protein Epitope Signature Tag (PrEST) antigen sequence
- ReactivityHuman
- Storage Instruction-20°C,2°C to 8°C
- UNSPSC41116161